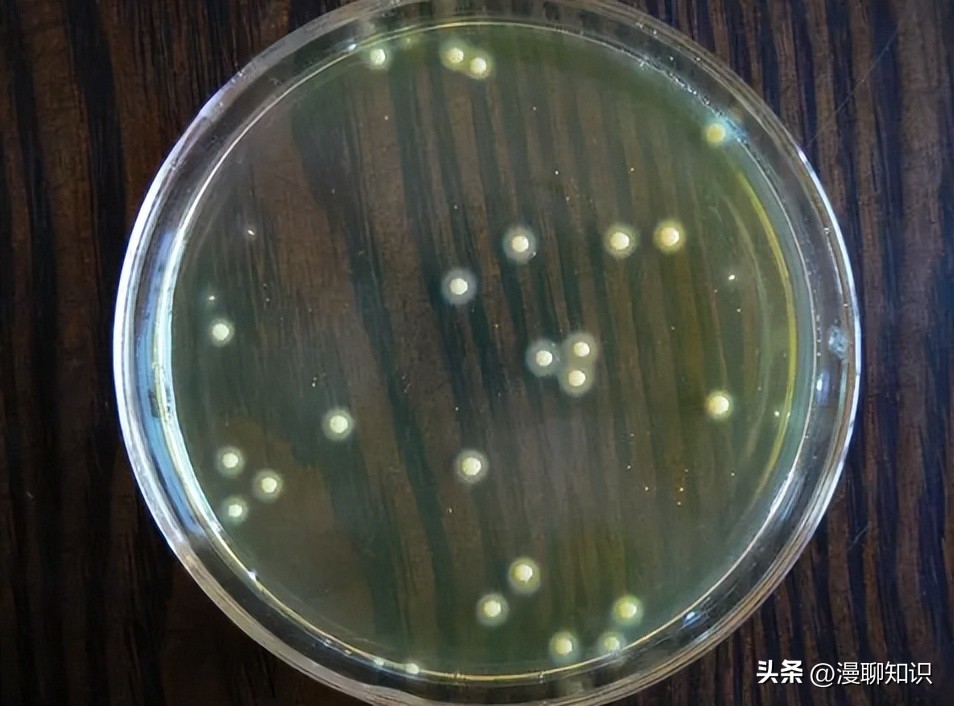
百毒杀对屏障系统灭菌率一般在64%~100%范围内,效果优于碘伏

阅读文章前,辛苦您点下右上角的“关注”,方便您讨论分享,持续关注每日优质内容~
百毒杀对屏障系统内饲育间天花板、地面和笼架的灭菌率一般在64%~100%范围内,并且其灭菌效果优于碘伏。
百毒杀按1∶600的比例稀释对屏障环境进行喷雾消毒可达到较好的效果;而对屏障设施进行擦拭消毒,将消毒液按照1∶100比例稀释杀菌效果最佳。
以上研究表明百毒杀对SA具有良好的杀灭效果,并且抗菌能力强于新洁尔灭。
建议以1∶100比例稀释的百毒杀用于屏障设施墙体和笼架等擦拭消毒;以1∶600比例稀释的百毒杀用于屏障设施空气的喷雾消毒,喷雾消毒量为10 mL/m3。

甲醛溶液是实验动物屏障设施常用的醛类消毒剂,对细菌及芽孢都有不错的效果,370~400 mg/mL甲醛水溶液(福尔马林)常用于空置动物饲养室的熏蒸消毒。
甲醛的熏蒸消毒灭菌效率高,能够杀死几乎所有微生物及孢子,杀菌效果极佳。
但该消毒液具有致癌性,毒性危害大,对实验动物及相关工作人员健康构成一定威胁,此外熏蒸消毒的流程也较为复杂。
甲醛主要通过使细菌蛋白质凝固,通过还原氨基酸使蛋白分子烷基化来实现杀菌的目的。
尽管普遍认为甲醛对革兰氏阴性菌的杀菌效力高于革兰氏阳性菌,但甲醛对于SA而言仍是一种极有效的杀菌剂。

王晓东等以甲醛熏蒸实验动物屏障设施并评价杀菌效果,发现甲醛对大鼠的繁育室的墙壁、地面和笼架的杀菌率分别为95%、100%和99%,对小鼠繁殖室墙壁、地面和笼架的杀菌率均为100%。
王慧等采用甲醛熏蒸法对屏障系统实验室进行消毒,结果表明甲醛对实验室中SA的杀菌率可高达99.8%以上。
甲醛溶液还能通过浸泡方式对屏障系统消毒,10 mg/mL的甲醛溶液浸泡固体2 h对SA的杀灭率可达99%。
以上研究表明,甲醛溶液是一种高效的杀菌剂,适用于屏障系统使用前的环境消毒或屏障设施被病原体污染的情况。
甲醛溶液建议使用400 mg/mL的浓度混合高锰酸钾或直接加热,按20 mL/m3的用量对屏障系统实验室熏蒸48 h, 可达到理想的杀灭或预防SA的作用。

戊二醛是一种广谱醛类消毒剂,可有效杀灭细菌和病毒,具有高效、刺激性小等优点。
戊二醛的杀菌机制类似于甲醛,主要通过与菌体蛋白质中的氨基结合使其变性或烷基化,从而破坏菌体蛋白。
戊二醛在屏障系统的消杀过程中,同样具有一定毒性危害,长期接触戊二醛的工作人员和实验动物,可能会产生慢性毒性及生殖致畸毒性。
研究表明,2.50 mg/mL戊二醛溶液具有良好的杀菌效力,可用于实验动物屏障环境的消毒。
唐蒙蒙等选择不同浓度的戊二醛溶液作用于SA,结果显示,0.4 mg/mL的戊二醛作用于SA 10 min可产生明显的杀菌效果。

戊二醛消毒剂易溶于水和有机溶剂,在酸性条件下稳定,但杀菌效力较低;在碱性条件下杀菌效力强,但不稳定。
王岩等应用0.3 mg/mL的戊二醛溶液作用于布片载体上的SA,结果显示消毒剂对SA的杀灭率达99.9%以上,酸性戊二醛需要10 min, 中性戊二醛则需要20 min。
酸性戊二醛消毒液对SA的杀菌效力强于中性戊二醛消毒液,这可能与消毒剂中含有强化剂相关。
以上研究表明戊二醛对环境中细菌的杀灭作用受到消毒剂自身pH的影响。
此外,戊二醛还能与癸甲溴铵作为复合剂联用,浓度为167 mg/L的该复合剂可在5 min内完全杀灭菌悬液中的SA(1×107 CFU/mL)。
戊二醛已广泛用于屏障环境消毒,常用20 mg/mL的戊二醛溶液浸泡屏障设施和塑料材质物体,也可用100 mg/mL的戊二醛溶液按1.06 mL/m3的用量对密闭空间进行熏蒸消毒。
二氧化氯常用于屏障系统的熏蒸消毒,相比于次氯酸钠,其毒性较低,刺激性较小。
该消毒剂在较宽泛的pH范围内均有效,并且对细菌、真菌、原生动物和病毒均具有强大的抗菌活性。
由于二氧化氯产生的三卤甲烷化合物少,因此它被国际公认为绿色环保的消毒剂,可用作自来水消毒剂。
二氧化氯发挥杀菌作用主要是通过其对细菌蛋白质造成不可逆的破坏。
同时,它可对菌体的细胞壁及细胞膜造成损伤,致使内容物泄漏;其强氧化性还可导致氨基酸链断裂等多种不可逆的损伤,从而发挥杀菌消毒的作用。

据报道,在含有蛋白质和脂肪酸的条件下,使用浓度为10 mg/mL的二氧化氯能在15 s内杀死MRSA菌株,并且其杀菌效力优于次氯酸钠。
液态二氧化氯作用SA 5 min后,对SA的杀灭对数值大于5;0.75 mg/L的二氧化氯溶液能完全杀灭菌悬液含菌量为5×108 CFU/mL的SA标准株ATCC6538。
由此可见,二氧化氯具有较好的杀菌效果。
此外,使用二氧化氯对实验动物设施进行熏蒸是一种清洁且高效的新型除菌方案。
但用于制造二氧化氯气体机器的成本一般极高,最近的一项研究表明,在较高在高湿度条件下(相对湿度约为80%),使用1 mL/m3的亚氯酸钠溶液接触二氧化氯气体(平均浓度为0.3 mg/mL)进行熏蒸消毒,能够完全抑制SA菌落的形成。
这一方案能够大大降低直接使用二氧化氯气体熏蒸消毒的成本,为实验动物屏障系统的清洁和消毒提供了新的思路。
推荐使用20 mg/mL的二氧化氯溶液按7 mL/m3的剂量对屏障环境及设施进行熏蒸消毒;二氧化氯还可用作屏障系统内的水体消毒,在1 000 L水内,其用量不应超过10 g。

微酸性电解水(slightly acidic electrolyzed water, SAEW)是一种新型含氯消毒剂,它是HCl或NaCl溶液通过电解产生的微酸性溶液(pH 5.0~6.5)。
SAEW对屏障环境和设施具有良好的杀菌效果,并且相比传统屏障系统消毒剂,SAEW能够很大程度上降低对环境的破坏和对人体健康的影响。
SAEW的杀菌作用一方面体现在其通过电解产生的氧化还原电位破坏了细菌细胞膜电位,改变了细胞膜通透性;另一方面,电解产生的活性氧和有效氯对细菌具有杀灭作用。
与同等浓度的次氯酸离子溶液相比,SAEW对食源性病原体,包括SA、大肠埃希氏菌和单增李斯特菌,均表现出更高的抗菌活性。

段弘扬等制备了一种有效氯含量为34.3~118 mg/L的SAEW,在含牛血清白蛋白的体系中,对金黄色葡萄球菌分别作用1、3、5、10 min, 其对SA的平均杀灭对数值均大于5。
据报道,SAEW还能有效清除细菌的生物被膜。
Yan P等使用25 mg/L的SAEW作用SA的生物被膜,结果显示,SAEW对生物被膜中的SA的杀灭对数值大于2.5。
由于SAEW极大限度减轻了氯气的排放,并具有较强的杀菌效力,其应用前景非常广阔。
屏障系统中可应用有效氯含量为80~100 mg/L的SAEW用于设备表面喷雾、擦拭消毒。

以上8种常用的屏障系统消毒剂对SA均具有较强的杀菌效力,但这些消毒剂存在各自的优缺点,在消毒过程中要依据各类消毒剂特点合理使用。
过氧化物类消毒剂不仅可以杀灭SA,还具有清除SA生物被膜的能力,可针对易形成生物被膜的细菌,但使用时要考虑到过氧乙酸及过氧化氢的刺激性和腐蚀性。
季铵盐类消毒剂对革兰氏阳性菌具有更高的杀菌效力,因此其对SA的消杀效果优于大肠埃希氏菌和沙门氏菌等革兰氏阴性菌。
醛类消毒剂是对细菌杀灭最为彻底的消毒剂,一般适用于屏障系统的熏蒸消毒。
醛类消毒剂对大肠埃希氏菌、铜绿假单胞菌及沙门氏菌等常见革兰氏阴性菌的杀菌效果略强于SA,并且这类消毒剂易造成实验室环境污染。
二氧化氯和SAEW属于清洁型的高效抗菌剂,对SA、大肠埃希氏菌、铜绿假单胞菌均具有较强的杀菌效力,但二者在制备过程中存在难度,并且使用二氧化氯消毒成本偏高。

SA能够通过环境传染给动物和人,并具有跨物种传播的潜在可能。
一旦实验动物感染SA,将对实验结果造成不可估量的损失,甚至还会引起饲养管理人员被感染。
尽管目前已有许多消毒剂被应用于杀灭SA,但它们在对实验动物屏障系统消毒过程中仍存在不同的局限性。
理想型消毒剂需同时具有高效、清洁、成本低廉、制备方便及稳定性高等特点。
因此,抗SA理想型消毒剂的研发亟待进一步开展。